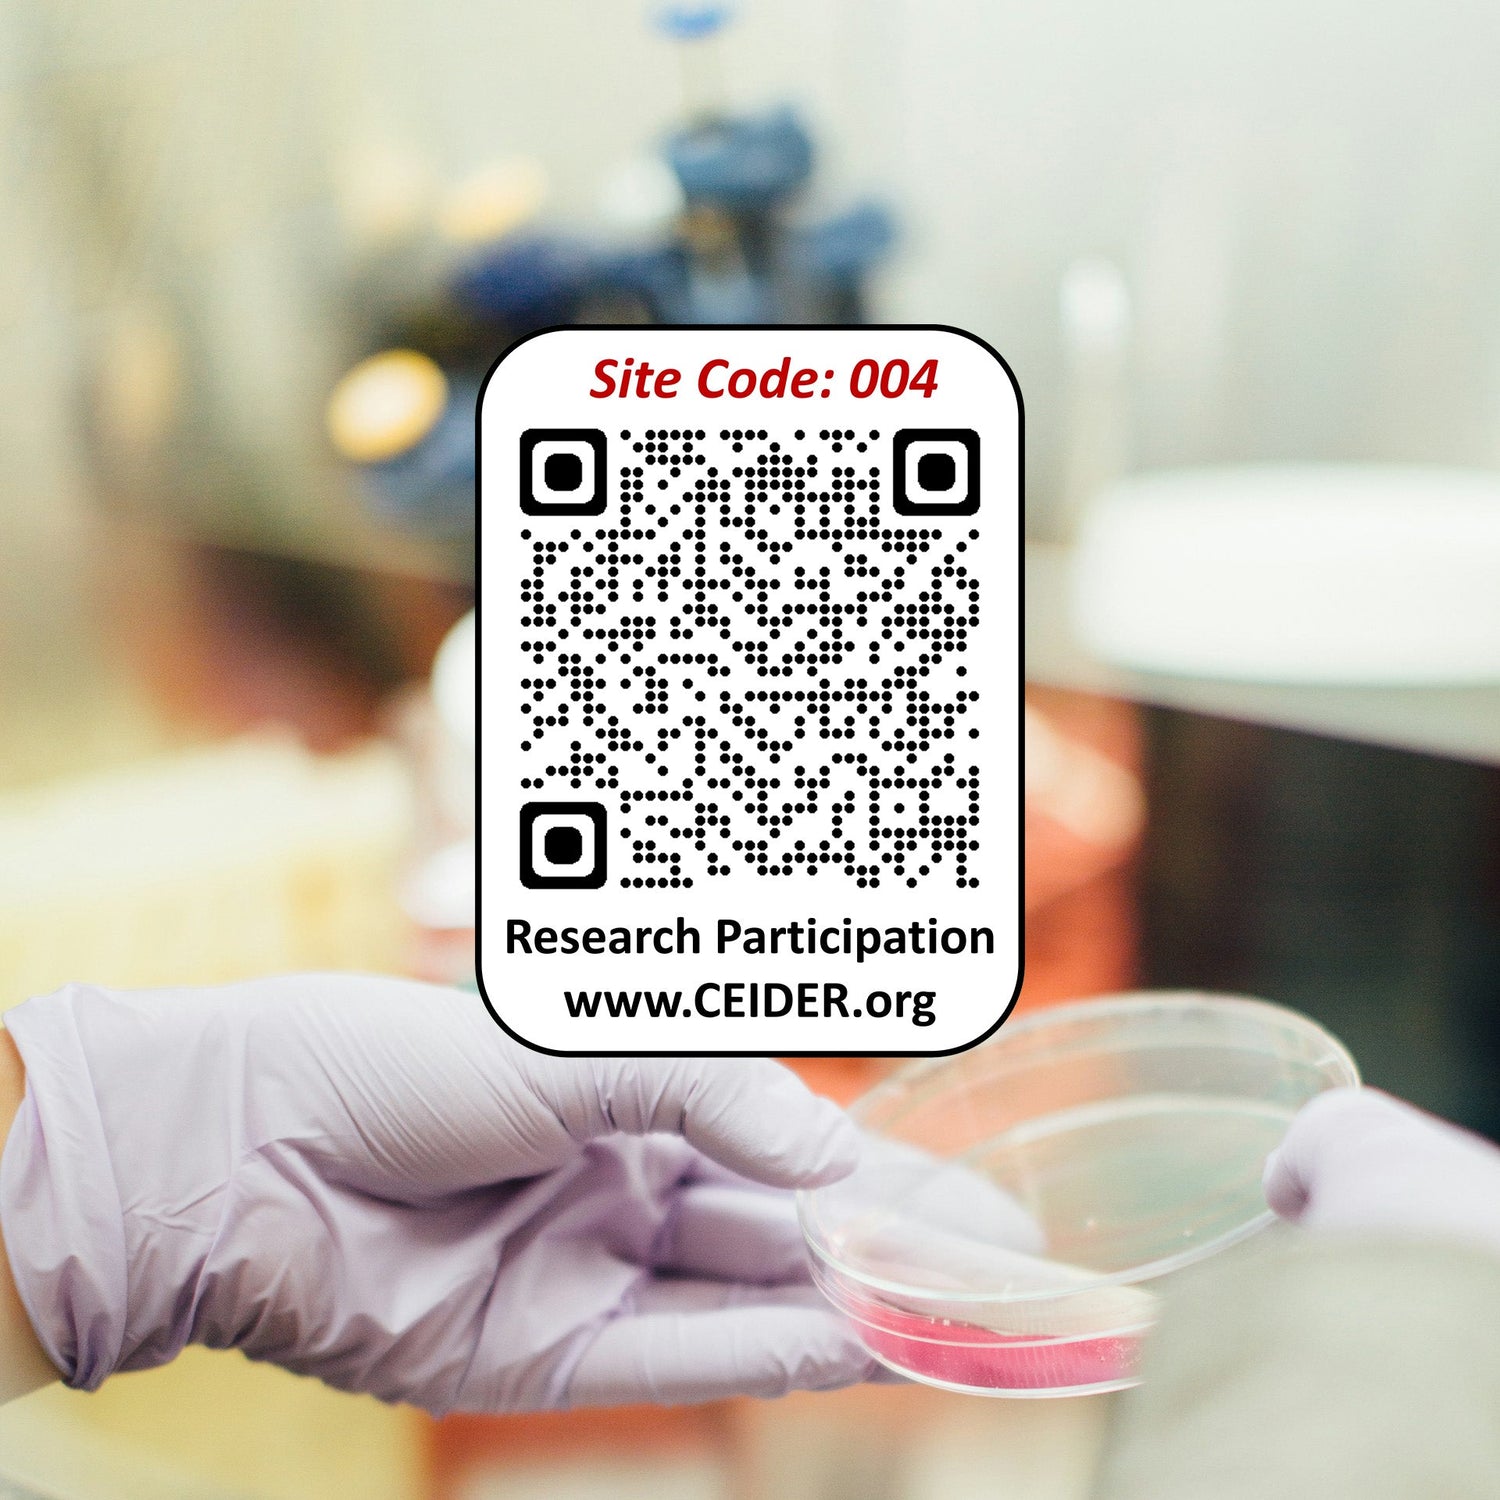

A science-backed memory support program designed to help you stay sharp by addressing key factors proven to support brain health.
Our mission is simple: To make effective, research-based tools available to everyone — giving you real, practical ways to protect your memory and brain health for life.
HOW THE PLAN SUPPORTS YOUR MEMORY

The Pronene Memory Plan has several key components designed to work together for cutting edge memory support.
As research advances, we will continuously update components of the plan, including supplement formulations, to guarantee you always have access to the most cutting-edge memory program available.